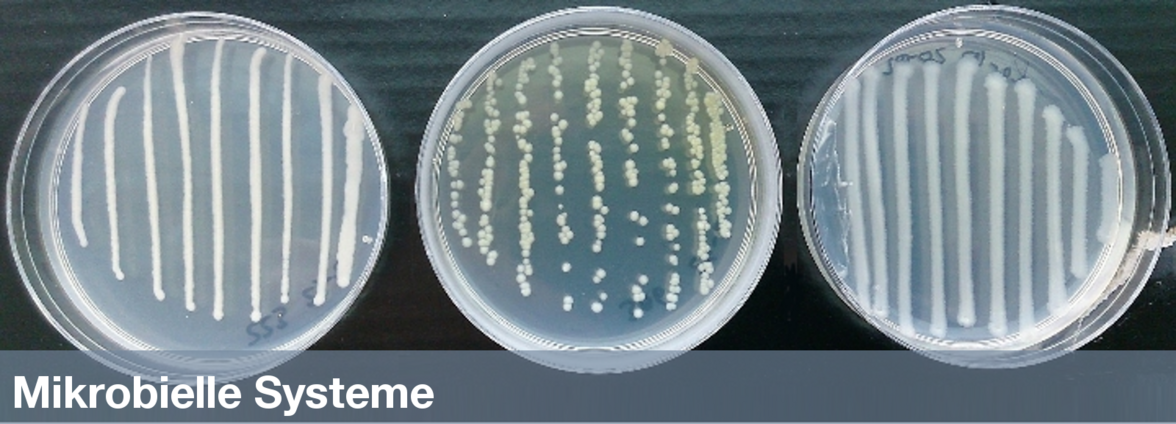

Welcome to the Chair of Urban Water Systems Engineering at the Technische Universität München. Our research activities are centered around sustainable, energy-efficient urban water and wastewater systems, energy recovery from wastewater and anaerobic technologies, storm water treatment and management, microbial systems, engineered natural treatment systems, advanced water treatment (membrane- and oxidation hybrid processes), water recycling, and state-of-the-art analytical tools for process control and water quality.